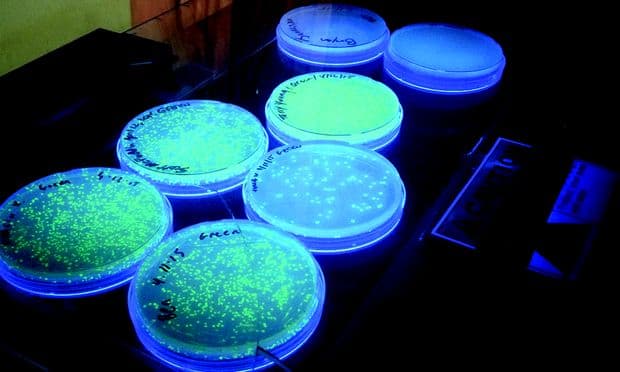
E-coli glows

Public radio’s longest-running daily global news program.
©2025 The World from PRX
PRX is a 501(c)(3) organization recognized by the IRS: #263347402.
Public radio’s longest-running daily global news program.
©2025 The World from PRX
PRX is a 501(c)(3) organization recognized by the IRS: #263347402.